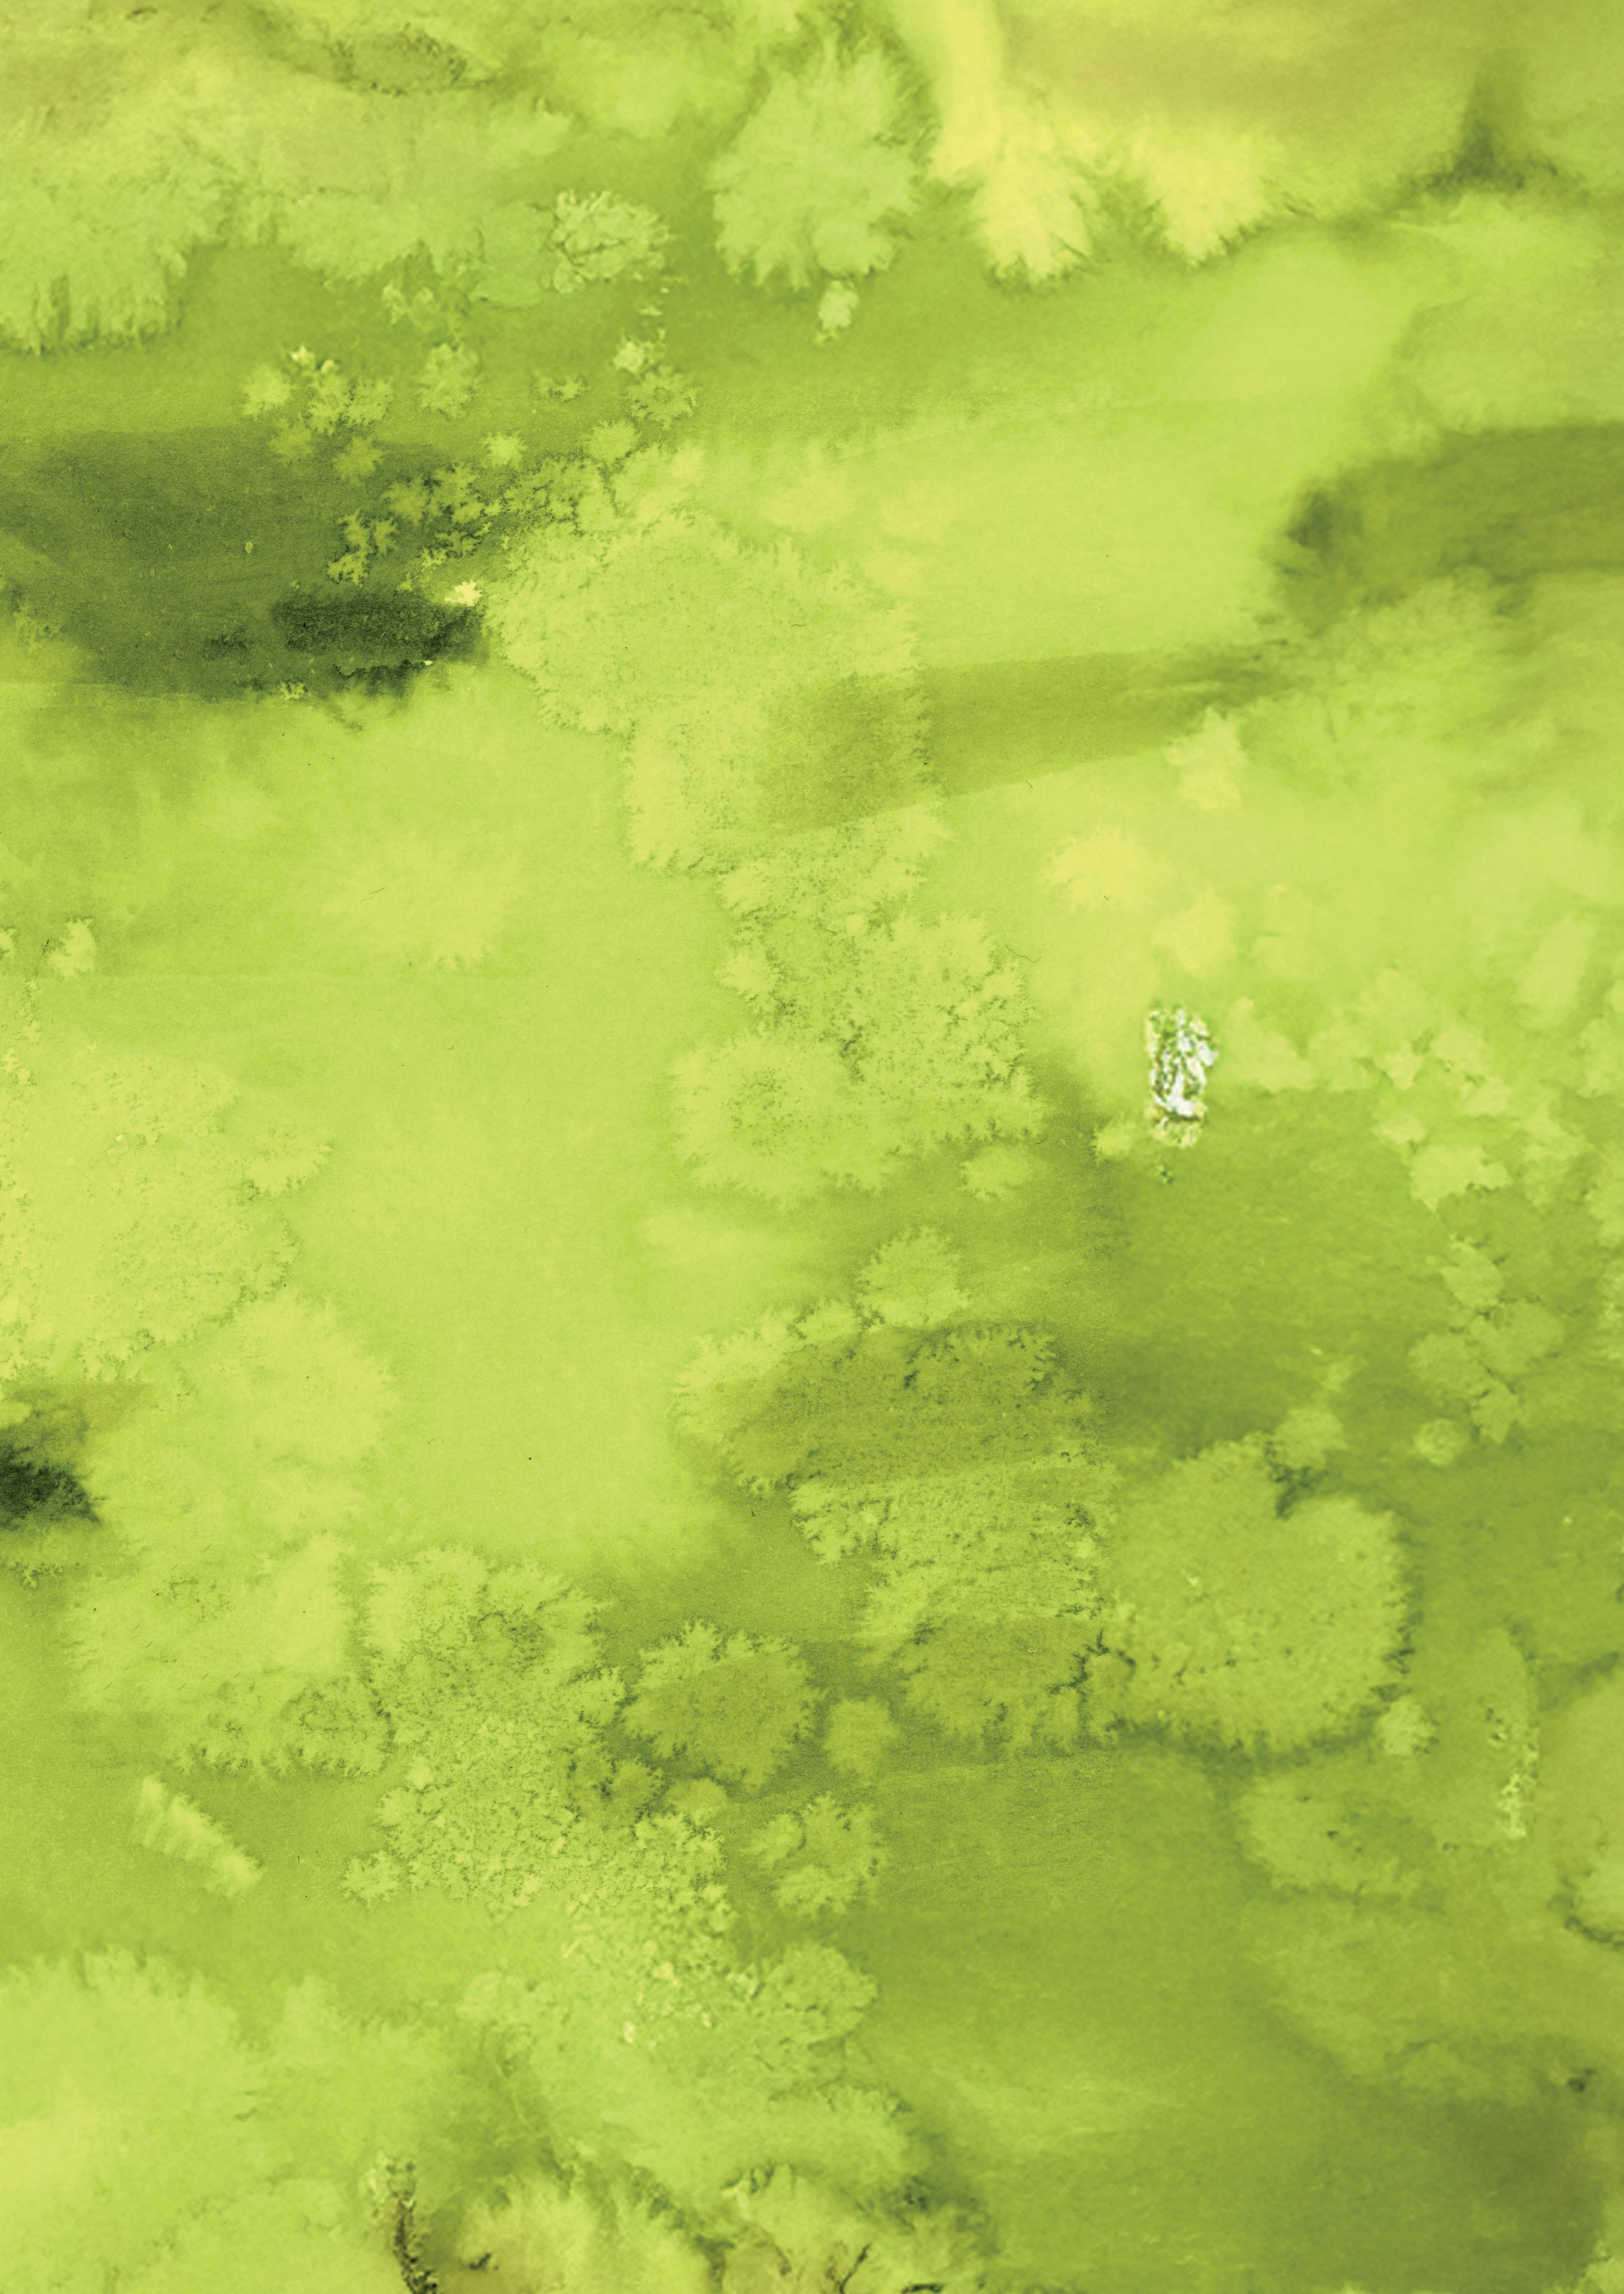

COLLECTIVE COMMUNITY
Coming together to celebrate our talents





















![]()

Coming together to celebrate our talents





















Reviewing this issue of the Muse and looking back at the Summer Term has been a particularly poignant experience for me. I was sadly forced to miss the last few weeks of the Summer Term, having been taken ill and put on medical rest. Watching from afar has been tough. I love the second half of the Summer Term: the longer days; the joyful induction events as we welcome new families to BGS; the fun of celebrating our current students at Prize Giving; the glamour of the Leavers’ Ball, and the wonderful Year 6 Exhibition, drama performances, art shows and concerts. It is my favourite time of the school year.
As a Head, there is always immense pride in seeing all that has been achieved and observing how much all our students have grown. Although saying goodbye to our oldest students departing for universities and the working world is always tinged with sadness, it is exciting to talk to them about their plans and ambitions. I have missed the day-to-day buzz of the school - the upbeat energy of the girls, the laughter, the chatter and the smiles in the corridor. It has reminded me of the total uniqueness of working in a school community.
My time away helped me to reflect on what an incredible community BGS is; I see how much we collectively undertake every day, to deliver an outstanding education for our students and how the students enthusiastically embrace all that we offer. I am fortunate to lead such a fantastic school. I would not have been able to take the time to fully recover if I hadn’t also been surrounded by an exceptional team who stepped in brilliantly in my absence. Knowing that I had such support from my colleagues and parents has made the world of difference; and I am extremely grateful.
I hope you can see some of our brilliance shine through the pages of this issue of the Muse: the sense of the strength of our community shining through at whole school events such as CultureFest; the creativity that was shown in our Year 6 devised drama production, and the articulate, bold and passionate voices demonstrated by our Sixth Form students ably leading the regional Model United Nations (MUN) conference.
I was particularly sad to miss Prize Giving; it is the most wonderful day. The words of this year’s guest speaker, the renowned journalist and broadcaster, Sally Biddulph, really resonated with the community. Sally is an alumna of Bedford High School and her focus on leaning into the pivots in life – seeing them as opportunities, not roadblocks – is so relevant for this generation of young people growing up in a constantly changing world. Like Sally, I changed my career
trajectory, leaving a burgeoning legal career to retrain in teaching. I followed my heart and have never regretted it. I love my job. Sally reminded the audience that finding the balance takes time and perseverance, but it can be achieved. She will have inspired many and entertained all with her tales from the newsroom.
I am proud of the fact that BGS students never shy away from new opportunities and our recently formed Triathlon Club is one such example. The popularity of triathlons has risen massively over the last decade, and it is important, where we can, that we offer students new sports to keep up with current trends. With our own resident world champion triathlete and Head of Swimming, Mr Castro, on site it is no surprise that our students have relished the chance to train with an expert. They have shown great resilience and determination as they start to finesse the techniques needed to master their new sport. I hope you enjoy reading their reflections.
Although having to go on medical leave was a shock, it has reminded me that we are very privileged to be custodians of BGS; ensuring that we look after each other, so that we can all continue to soar is so important.
I am looking forward to returning to school for the start of the new school year in September. I can’t wait to welcome our new families into the school and reconnect with our existing students. I know there will be a lot to catch up on, but we have exciting plans to move ahead with as we continue to invest in the quality of our education.

We help them build not only intellectual confidence but self-belief, resilience and wider understanding of the world.
Gemma Gibson Headmistress


Nawaal Qazi is the current BGS Head Girl 2025/26 and she is studying Chemistry, English Literature and History at A Level. She is the co-founder of the BGS Law Society and is an aspiring barrister.
Former Head Girl, Jane Leech MBE (née McKendrick, BHS 1982), is our new Chair of The Alumnae. Following school, Jane read Law at Wadham College, Oxford and began her career in the City at international law firm Lovells (now Hogan Lovells), specialising in commercial litigation.
In 1999, Jane took a career break when her husband was posted abroad, and for over a decade after their return to the UK, Jane combined raising their four daughters (all former students of BHS and BGS) with studying and volunteering. In recognition of her work with the Independent Monitoring Boards at Yarl’s Wood Immigration Removal Centre, Jane was awarded an MBE in 2020.
She has just taken up two new voluntary roles: as a trustee of the charity Link to Change, and as an Independent Custody Visitor, monitoring conditions in the Kempston and Luton Police Custody Suites.
Reflecting on your first day at school, what memories stand out to you the most and how did they shape your experiences?
Nawaal Qazi (NQ): On my first day ever at BGS, I knew no one and so was incredibly nervous. Given the unfamiliar environment, I remember bringing in the map I’d been given on my induction day. I assumed it’d make it easier to find my way around; it did not. It was a few minutes before the time my class started, which is considered ‘late’ to most Year 7s, so naturally I panicked.
I was forced to ask for help, which was the worstcase scenario. Who would I ask? How would I ask? What will they think of me?
Before I knew it, a fellow student appeared. It was now or never, so my body instinctively blurted out the words: “Sorry to bother you, I just wanted to ask if you knew where MOO1 is?”
Frozen in the moment, bracing myself for how the fellow student would laugh at me and there’s no way I’d make it to class on time.
“Over there.” She pointed at the class behind me, which was an even more foolish scenario than being late, “If you go now, you’ll be able to make it on time.” Smiling, she expressed no judgement whatsoever.
She taught me two valuable lessons. Firstly, asking for help can save you and secondly, despite what we assume, it won’t kill you.
Jane Leech (JL): I remember joining Form 1, aged 7 and Miss Mortimer was our form tutor. I recall more from Lower 2, where we were kept in order by Miss White. She had high expectations of good behaviour and liked silence in class –which was the rule throughout most of my time at school.
I also remember the Head of the Junior School, Miss Machell, a Classicist who was an ardent rule -follower and ran the school with a rod of iron: it was a much less nurturing environment compared with today’s Junior School! I knew from early on that there was an expectation of good behaviour and academic achievement throughout my schooling.
What are your favourite subjects and why?
NQ: My favourite subjects all began as my least favourite subjects, mostly because of how difficult I found them in Senior School. With a little encouragement and a lot of hard work, I realised that their challenging nature is what makes them enjoyable. Now, I take them at
A-Level. Although, sometimes they’re demanding enough to have me questioning my choices…
I’ve always loved reading storybooks, so English and History opened me up to a new plethora of reading mediums. Articles, journals, essays, poems, blogs, magazines etc. Which are all interesting but different ways to gain insight into the minds of people. However, the best part about them is how seeing diverse perspectives can, and will, change a narrative. It also allows me to be creative, I really do believe that writing is an art form - a painstaking, yet rewarding art form.
Maths was also always one of my strong suits but I didn’t pursue it (much to my parents dismay) because I didn’t enjoy it as much as Chemistry. I could gain the satisfaction of solving a difficult chemical problem, sometimes taking hours, and see its application to the real world.
JL: I adored French and History and went on to study these subjects at A Level. I had such encouraging and inspiring teachers. I leaned more to European History and Mrs Dickey always sparked lively conversations in this area. There was always so much to talk about.
If you could have your school years again, is there anything you would do differently?
NQ: Many have heard of the saying “time is money”, but I’d like to rephrase that in a way I see more fitting: time is the most valuable currency we have.
After all of these years, if there was one thing I’d do differently, it would be making the most of the school time I had. The best way of doing so? Participating in more extracurricular activities. I didn’t see real enjoyment until I joined the debate club.
Clubs weren’t really my forte, due to a combination of being shy and reluctant. But that day I loved it so much that I kept participating, even when my friends left. I met new people, learnt new skills and discovered new things I became really passionate about.
Now, I take on every opportunity that arises; Model UN, Law Society, Amnesty and more. Nevertheless, my point still stands, time is the most valuable currency we have, and these days, I can barely afford it.
JL: I would not have worried about things so much. There can be a lot of expectations put on individual students from a young age and I would advise my younger self not to submit to the pressure so much. In that respect I think things have changed for the better.
How has the school environment and teachers contributed to shaping your values and aspirations?
NQ: Something I like about BGS is how, when I walk around the halls, I’m able to smile at students from all year groups and teachers from all departments. This is because BGS is a closeknit community, where many of us get to know each other due to its comfortable and welcoming nature.
Even people I know who joined school at later stages are recognised by everyone in their year group within a matter of weeks. You see people at clubs, at lunch, at house events, everywhere really. Which sounds daunting but, actually, it harbours close, lasting connections.
With that, everyone understands both your struggles and motivations and it creates a supportive environment like no other.
Teachers and students alike pushed me to strive for the best and showed me the value in doing the same for others. It is an attribute that brought me far, and one I’d like to carry into my future.
JL: School was a rigorous and academic environment. I clearly remember Mrs Molian’s rules on grammar and writing, which stood me in good stead in my future career in Law and in my voluntary work. I enjoyed the precision of what was I being taught. I also formed a lifelong interest in languages and I am currently enjoying learning Italian.
School also encouraged my love of sport and an understanding of the importance of teamwork. The legendary Mrs Bullerwell (then Miss PrysorJones or “PJ”) was our Head of Sport at BHS and I took part in the first hockey tour to the United States in 1982. It was a truly wonderful experience and has had a lasting impact on me. It also inspired me to become a trustee of the Fellowship Fund, supporting today’s students with financial assistance for trips and other educational projects.
What has been your best experience as Head Girl so far?
NQ: Every time I perform a speech, without a doubt, someone will tell me: “I could never do that, I’d absolutely hate it.” And they aren’t wrong, there are lots of annoying aspects of the speech process, but there are also lots of gratifying aspects.
From tirelessly writing and rewriting drafts to craft the perfect speech. To practise it over and over, making sure not to mispronounce something as simple as my name. To emotively deliver it on the day, acting it out as a performance and attempting to captivate my audience.
Arguably one of the most important parts is the feedback afterwards. Of course, I especially enjoy the praise but I also appreciate pointers. It helps me improve each time I perform again, and allows me to meet varied people. Although, the absolute best aspect, and what I enjoy most, is having an impact.
At prize-giving, I performed to an abundance of people and heard much about my speeches, but two young students stood out. They told me how they related to my speech and the story I shared, feeling motivated that things could work out because of it. Hearing that made it all worth it.
JL: My year as Head Girl coincided with the School’s Centenary year and I remember there being lots of celebratory events. I felt very proud to represent school by reading a Lesson at a commemorative service at St. Peter’s church.
I also remember weekly meetings with the formidable Head, Mrs Kaye, and leading her into school assemblies.
The Head Girls’ team was much smaller than it is today so we became very close and I remain great friends with one of my deputies, Kate Lanz, to this day.
Sum up your school days in three words or more?
NQ: Busy, social, stimulating and enjoyable.
JL: Strict, but happy! And lifelong friendships.




This year’s Year 6 production of Mr Merlin’s Magical Antique Shop took a wonderfully imaginative turn, as students devised and performed their own play from scratch.
Mrs Sarah Horton, Drama Teacher, explained: “Rather than working from a script, the students were challenged to being with a collection of unusual props and costumes and were asked to reimagine them entirely. The only rule was that the object couldn’t be what it actually is.”
Soon, the stage was filled with stories. A hat that revealed your thoughts, a witch’s enchanted bucket, an alien’s communication stick. In small groups, the students built characters and narratives around these objects, developing them through workshops supported by a team of Year 9 students.
“It was the most incredible experience to help develop a show from scratch,” said Harriet, part of the Year 9 backstage and directing team. “It was amazing seeing all the creativity as they had to make it up themselves.”
For the Year 6 cast, this approach brought new energy and excitement to the experience. Bella, Year 6 reflected: “The way we were encouraged to make a creative piece by ourselves made it feel like the play was really our own. I don’t think any of us realised how amazing it would be until we performed it.”
Mrs Horton added: “Each rehearsal started with the students watching back the footage of their first improvisations. From there, they could really reflect on what worked and what they wanted to develop further. It gave them a sense of ownership from start to finish.”
Alongside the devising work, older students supported not only as backstage crew but also as mentors and co-directors, helping guide the younger performers and contribute to set and prop design.
Holly, Year 9, said: “Working backstage was an amazing experience and helped me develop my leadership skills. The Year 6s were brilliant and worked so hard.”
Karin, Year 9, added: “Now when I walk around school, the Year 6s wave and smile. It was such a lovely connection to make.”
Sanya, from Year 6, shared: “I liked making our own scenes and having the experience of a live performance. We all thought it would be a normal play, but I think what we created was out of this world!”
Each group refined their scene with support from staff and student mentors. The result was Mr Merlin’s Magical Antique Shop, a devised play in which each unsuspecting customer is transported into the imagined
history of an enchanted object. From mythical kingdoms and historical moments to Barbie Land and game worlds, every scene brought a new surprise.
Mrs Horton said: “The play became a patchwork of their voices. Each group’s scene was shaped entirely by their own ideas, and that gave the final show a real sense of joy and originality.”
Jess, Year 6, said: “I enjoyed the Year 6 production so much. I was most proud of my song because I was really nervous to sing it, but I did it. I made so many new friends and got to spend three nights dancing and having fun with them. It was a dream come true.”
The play followed a clever structure, with characters becoming trapped in the antique shop, cursed to become the next owner, before new customers arrived to take their place. The story built to a high-energy finale as the cast came together on stage.
“The night of the performance was a whirlwind of craziness and fun,” said Sylvia, Year 9. “It was a perfect mix of hard work and exhilaration.”
Eva, Year 6 said: “I loved the thrill of heading on stage and being able to act like my life depended on it. It was so special and has a lot of memories along with it.”
The final scenes were filled with humour, music and energy, featuring Queen’s I Want to Break Free and a celebratory dance to Pitbull’s Fireball
Olivia, Year 9, reflected: “The Year 6s were having the best time. Even with Duke of Edinburgh in the way, we still made it back in time for the final Saturday performance. There’s nothing I would change about it.”
Ekam in Year 6 added: “We learned new things, made new friends and, most importantly, improved our acting skills. I really enjoyed our scene. It was stressful at times, but also fun and exciting.”
Laina, Year 6, added: “It really brought us together in a magical way.”
Mrs Horton concluded: “What we created wasn’t a traditional school play. It was a devised piece, shaped entirely by the creativity, energy and collaboration. I’m incredibly proud of what they’ve achieved, and I know the audience enjoyed watching it as much as we enjoyed making it.”


This year saw the launch of Bedford Girls’ School’s first Triathlon Club, and it has been an exciting journey for all involved.
Led by Mr Ed Castro, Head of Swimming and an eight-time World and European Triathlon Champion, with support from Mrs Davinia Inkson, Head of Year 6, the club introduced students to the fast-paced world of multisport racing. Triathlon combines swimming, cycling and running into one continuous event, with the added challenge of smooth transitions between each discipline.
The club opened in January to students from Years 4 to Upper Sixth. Early sessions took place indoors, focusing on swimming skills in the pool, indoor cycling and running, and the basics of transition. As the weather improved, the club moved outside with early morning sessions at Cople Fields, where students brought their bikes for a practical mix of cycling, running and transition training.
Mr Castro explained: “Triathlons have become a popular discipline and I am really happy that we are able to offer the training in school. It demands more than just physical ability. You need to manage your time, prepare your kit, and stay focused. It’s not just about being fast, it’s about thinking clearly when you’re under pressure.”
Throughout the year, students have shown commitment and curiosity. The pre-school sessions have been well attended and many athletes have chosen to come in for additional swim sessions to improve technique and fitness.
The club has also explored triathlon-specific equipment, such as number belts, elastic laces, and even the practicalities of using Vaseline and talcum powder to save time and avoid discomfort.
“The students have embraced every part of it,” Mr Castro said. “They’ve been keen to try things, to ask questions and to keep improving. Whether it’s someone attempting a flying mount onto their bike or learning how to pace themselves over a longer distance, everyone has made progress in their own way.”
Triathlon has offered more than just physical challenges. Students have built valuable life skills, including time management, organisation and selfdiscipline. These are qualities that will serve them well both in and beyond sport. Several have taken on disciplines they had previously found difficult, while others gained confidence through trying something entirely new.
A strong sense of camaraderie has also developed throughout the year, with students encouraging one another and sharing in each other’s progress. From working on transitions together to turning up on chilly mornings with enthusiasm, the sense of shared purpose has been clear.
The club’s first competitive event was the Bedford Junior Aquathlon in March. Many of the students were taking part in a multisport event for the first time and were keen to apply their transition skills in a race setting. The experience built confidence and set the tone for what was to come.
In May, eight students from Years 5 and 6 represented the school at the IAPS Triathlon Championships at Monkton Combe School in Bath. Competing against schools from across the country, the students completed swim, bike and run courses tailored to their year group, while managing transitions across a technical and hilly route.
Mr Castro reflected: “It was great to see how they handled it. This was a tough course, not flat and certainly not easy, but they applied what they had learned. That’s what training is for. They went in prepared, gave their best, and supported one another from start to finish.”
The triathlon programme has encouraged students to develop across all three disciplines, but also to approach each session with independence and a positive attitude.
Mr Castro added: “It’s been more than just sport. Our students have learned how to look after themselves and each other, to commit to something and see it through. That’s what will stay with them as we move into our second year and hopefully compete in more events.”
The first year of Triathlon Club has laid strong foundations, with students gaining fitness, confidence and friendship along the way. There is already great enthusiasm for what lies ahead.

After months of planning, CultureFest returned to BGS on Saturday 28th June, bringing the community together to share, connect and celebrate the many cultures that shape our school.
The field came alive with games, creative activities, stalls and delicious food as students, parents and staff all participated in running the day to ensure it was a tremendous success.
In the main tent, a programme of live performances unfolded, including Bollywood, Sega and Salsa dancing, music and choral performances, as well as student-led acts. Miranda, Year 5, who performed a Venezuelan dance, said: “I was really nervous when I got there and I didn’t think I could go on stage alone. My friends encouraged me to go and do my dance, and once I started I got more confident and I felt really proud to be able to represent the music from my Venezuelan culture. It was so fun!”
Miranda’s mum added: “Preparing a dance for Miranda to do at the festival was a fun family experience. We were surprised she did it even better than when she had rehearsed it, despite the nerves. All the performances were beautiful and the different stalls had a wide variety of items to buy, and the food was delicious. Well done to the organisers and teachers, it was a lovely day.”
The Junior School choir sang beautifully, with friends and family enjoying ice-creams whilst listening to their lovely voices from the comfort of colourful deck chairs, keeping them cool from the heat of the sun.
Rosie Freear, Lower Sixth commented: “Seeing everything come together for CultureFest was amazing! Everyone worked so hard on their stalls and performances, and this really shone through. I loved being able to share a musical composition I had been working on, and the Junior Choir’s performance was impressive. It’s lovely to see the girls’ enthusiasm in getting involved with different cultures, and it certainly brightened my day. Refreshments and food demonstrations were a relief against the hot weather and I had a great time planting my own thyme at the sustainability stall.”

One of the most popular features was the food demonstration tent, kindly organised by The Association (PTA). Families gathered to learn about traditional recipes from Libya, Mexico, Pakistan and Lebanon, watching dishes being prepared and sampling flavours from around the world. Everyone was also kept hydrated with Mrs Sira’s, Chair of The Association, delicious chai and popular mango lassi.
BGS parent, Mrs Bradford, who organised the food demonstrations, commented: “We were blown away by the success of the CultureFest food demonstrations. Our chefs were amazing! It was so lovely to watch them share their cultural dishes with the BGS community and to see everyone enjoying the delicious tasters throughout the afternoon. It was clear to see the passion they have for their cooking and heritage.”
Mrs Sherine Swan, Head of Geography added: “It was lovely taking part in an event that celebrates the many cultures within our school community. Sharing a dish of fattoush, such an integral part of Lebanese cuisine and daily life, was a special moment. It reminded me of home.”
Mrs Sira, Chair of The Association, agreed: “CultureFest was a vibrant celebration of diversity, community, and togetherness, and it simply could not have happened without the wonderful support of our parent community, creating such delicious food.”
“The festival was a proud moment for us all, a joyful and inclusive event that brought our school community together in a spirit of unity and appreciation for all cultures. It truly reflected one of our core values here at BGS: celebrating diversity and fostering inclusivity. I felt especially proud to be part of such a remarkable day. The positive feedback we’ve received from the day itself and in the days following has been heartwarming.”
Our younger students joined in with enthusiasm, with each Junior School year group helping at stalls and welcoming visitors. Mrs Sabrina Simms, Business and Economics Teacher reflected: “It was amazing to see the Junior School students so eager to help at our Young Enterprise toy tombola. They worked hard, had fun, and looked brilliant in their CultureFest outfits.”











Each of the Upper Sixth Girls’ Leadership Teams (GLG) took responsibility for running different activities – from hair braiding and bracelet making to traditional garden games, they all provided plenty to keep the busiest of students happy.
Sophie Wilshin, Lower Sixth who ran the Eco-stall, said: “The Eco-stall run by the Sustainability Team was selling the BGS reusable cups as well as some plant pots that customers were able to decorate themselves. With an emphasis on reusability and recycling, we were also giving out free bags of coffee grounds. These came from the Sixth Form Café, Chequers, as waste from the coffees, so we were pleased to hand them out and help reduce school waste. We had lots of conversations with both students and parents about the importance of sustainability and initiatives that can help the school reach its sustainability goals. Overall, it was a lovely event and we were very pleased to have raised money for the school charities.”
The cultural fashion walk arranged by the D&I team was a big highlight of the day for many of our students, giving them a chance to proudly show off their colourful outfits.
Meanwhile, our entrepreneurial students and alumnae demonstrated a vast array of creative skills, with stalls selling their homemade jewellery, key chains, beautifully decorated pots, crocheted toys, plants and sweet treats. Their hours of hard work paid off with a roaring trade!
As compère, Mr Matt Gracie, Deputy Head, Student Engagement and Welfare, commented: “It was so lovely to share an afternoon as a wider

school community, celebrating every student and the breadth of cultures in our school. This is such an important aspect of our ethos and at the heart of the life of BGS; it was wonderful to see the warmth and friendship of the BGS community on display.”
He added, “The support of families with cooking demonstrations, enabling small business stalls, donating and purchasing, made the event a great success in our eyes. It was also a delight to have family members join our amazing students on stage to perform, showing the breadth of talent around us. The buzz of the event was brilliant and the hard work of all the staff who helped put it on felt thoroughly worthwhile to create such a memorable afternoon.”
Mrs Katie Tombs, Catering Manager, summed it up perfectly: “CultureFest 2025 was an incredible celebration of our BGS community. Seeing the pride and excitement of students as they displayed their talents and cultures was electric. The sunshine was just the icing on the cake. It is events like this that make BGS so special.”

“You might avoid politics in small talk to steer clear of controversy, but at BGS Model United Nations (MUN) 2025, we welcomed it.” Nawaal Qazi, Head Girl and BGS Secretary-General.
On Friday 13th June, Bedford Girls’ School successfully hosted its third Model United Nations (MUN) conference, welcoming delegates from five schools: Stephen Perse Foundation, Caroline Chisholm School, Bedford Modern School, Bedford School and Bedford Girls’ School.
MUN is a simulation where students take on the roles of world leaders and diplomats to debate global issues and work together to find solutions. It has become an annual tradition at BGS.
Planning began months in advance. Nawaal explained: “Our preparation started well before the summer term. We worked hard to ensure this would be our best conference yet. There is so much that goes on behind the scenes that people don’t always see.”
Sonia Erwig, Co-General Secretary, BGS Lower Sixth, reflected: “What many attendees might not realise about this conference is just how much organisation, coordination and dedication went into bringing BGS MUN 2025 to life. We had to ensure that delegates received study guides, placards were printed, folders assembled and classrooms transformed into international meeting halls in time for the conference. Planning a largescale student-led event is no small feat. We faced unexpected hurdles but careful planning, constant communication and a shared sense of purpose kept us on track.”
On the day of the conference, the theme was introduced in the opening speech. Nawaal said: “We chose this year’s theme, The Price of Life, because in today’s rapidly evolving world, questions surrounding the value and cost of human life are at the forefront of international discourse. These ideas were also at the heart of our conference.”
Delegates explored the theme through the unique focus of each committee:
• Crisis Committee.
• United Nations Office on Drugs and Crime (UNODC) – Combating Child Recruitment by Drug Militias: How to Protect Youth from Criminal Exploitation.
• World Health Organisation (WHO) – Evaluating the Legalisation of Euthanasia and Its Implications for Global Health Policy.
• World Trade Organisation (WTO) – Balancing Protectionism and Affordability: The Impact of Tariffs on Essential Goods.
• United Nations Human Rights Council (UNHRC) – Safeguarding Human Rights in the Context of Peaceful Protests and Assemblies.
Guest speaker Sarah Owen, MP for Luton North, who brings a wealth of experience to MUN from her youth, was unable to join in person as she was attending Parliament for the Assisted Dying Bill. Instead, she sent a video message, reminding delegates of the importance of listening to one another. Afterwards, committees got underway and delegates began debating.
The day was filled with humour and fun, balanced by thoughtful discussions and spirited argument. Above all, it was filled with open and honest conversation.
Safa Akbur, Year 10, described the event as “fun and engaging,” adding, “it was a really good experience.”
Zara Saleem, Year 10, said: “As a less experienced delegate, there was much less pressure than I usually feel. The chairs were great at guiding us and organised the conference in a way that made sure everyone knew what they were doing and could enjoy themselves.”
Izaan Aris, Bedford School, Lower Sixth, commented: “As a chair from a different school, there was no awkwardness at all in bringing together students from so many places. I felt we could all talk easily because everyone was just as passionate and excited as each other.”
Nawaal reflected: “This was my first conference as a Secretary-General, stepping away from my usual role as a delegate. It was truly eye-opening to see the event from the other side. What struck me most was how committed everyone was, and how well-researched and thoughtful the debate became throughout the day.”
The event culminated in a series of resolutions drafted and debated by the student delegates, tackling a range of complex global issues.
“In my closing speech, I reminded everyone that despite the fun, there is a deeper purpose to doing Model UN. We are often told that change is out of our hands, that it’s something only institutions like the UN or politicians









can achieve. But the truth is, those institutions only exist because of the people behind them. Our generation is the one who will inherit today’s choices and tomorrow’s consequences. Political awareness isn’t just important, it’s vital,” said Nawaal.
She added: “Seeing so many passionate and articulate students tackle global challenges gave me real hope for the future. It showed me that we will not shy away from difficult questions. We will face them, challenge them and try to do better. That was the spirit of this year’s theme, and our delegates absolutely rose to the challenge.”
Mrs Barber, Head of Business and Economics, commented: “The success of the BGS MUN conference is only possible because of the work that goes into organising the day. At the start of the Spring term, the Lower Sixth students began working on their ideas for the day and the roles they would take on. From this, the General Secretaries – Nawaal, Sonia and Shazmin – began planning the day, while the Chairs – Danae, Aakriti, Mia, Moksha, Aathmika, Mitali and Rhiana – agreed on the topics they would be debating. After considerable research, committee guides were prepared and visiting schools contacted.
“Various teams within the school also supported the event, including IT, Catering, and Premises. As the day drew nearer, the Lower Sixth students focused on specific tasks including writing speeches, printing certificates and preparing presentations. They showed great teamwork and commitment throughout the process.”
Nawaal concluded: “On Friday, we came together. Whether to debate ideas, share perspectives or simply learn from each other, we were doing more than debating. We were practising diplomacy. The kind of diplomacy that can, and must, change the world.”







It was with great anticipation that ITV News came to BGS for our Senior Years Prize Giving, as we welcomed our guest speaker, newsreader, Sally Biddulph, who inspired and entertained the audience with her reflections on her education at Bedford High School and how it has helped shape her career in national news.
Starting proceedings with the iconic News at 10 bongs, Sally Biddulph described her life as a series of pivots and mini pivots which had created the path she eventually followed. From how she had persevered to attend the University of her choice (Cambridge on the second attempt); taken bold action to change her career direction when her commercial graduate programme wasn’t fulfilling her ambition; and how she came to realise her passion was the telling of stories, combining her love of languages, communication and travel.
In a career that spans over 20 years, Sally has worked across local, regional, national and international radio, print and TV, covering
everything from royal news to breaking stories of national political importance.
Sally regaled the audience with tales from the newsroom and explained the adrenaline and excitement of being at the heart of breaking stories: “Another key political change was the handover of power from Tony Blair to Gordon Brown. I was presenting a live broadcast in front of parliament for Central News. With 30 seconds on air, the autocue failed. Again, a big pivot; I did 15 minutes of telly, introducing reports, interviewing politicians with just hard copies of notes in my hand… always, always print off scripts before going on air. That shuffling of papers at the end of a news bulletin is the backup scripts you hope you never have to use!”
A key highlight of Sally’s career was presenting the newsflash that told the nation that Princess Charlotte had been officially named. Sally recalled that: “ITV News was first to air, and I was insanely nervous, but those 20 seconds of telly were a career first, I broke a global story.”
Sally spoke poignantly about being inspired into a life of storytelling by hearing about the iconic foreign correspondent, Kate Adie in a school assembly. She recalled how certain teachers shaped her aspirations and skills, including Madame Barnes and Frau Ross (in the audience).
Sally reflected that at the centre of all she does is the repeated desire to tell someone’s story; to show the best and the worst of humanity. She explained how some of those stories will haunt


you: “Most recently the Southport stabbings. They were horrendous to report on, especially as a parent. Likewise, the inquiry into the 7/7 London bombings with testimony from survivors and acts of superhuman heroism. I ended one of my reports with the words ‘What would you do, how would you act, what would you say if a stranger lay dying in your arms?’ I will never forget it.”
“But then of course there are ‘and finally’, the much-needed lighter fun stories at the end of the bulletin. Reports like the British boy who won the European seagull screeching competition, yes really… and the UK’s loneliest sheep, named Fiona, who was rescued after being stranded for two years at the base of cliffs in the Scottish Highlands. I covered both of these and they both made it onto Gogglebox, another career high!”
In what we think is a BGS first, Sally interviewed another BGS alumna. “I also unwittingly interviewed another alumna of this school, the brilliant mountaineer, Fay Manners, who actually gave this Prize Giving speech last




year. I did a Zoom interview with her after she was rescued while high up in the Himalayas. I covered her remarkable story of survival for the lunchtime news and I spoke to her from the safety of a hostel in Kathmandu. I only realised she was a former Dame Alice girl when I read it in The Alumnae magazine!”
These days, Sally is based in the studio rather than reporting out and about. Another pivot, which means she can have a balance between work and being a mum to twin teenage girls, who she describes as “My greatest story, my personal scoop, my biggest achievement.”
Sally’s stories engaged the audience, highlighting that it is sometimes those small moments, through school and university, that can often gradually inform your choices. She showed that it is resilience and determination to follow your dreams which will create a life that you will be passionate about. Her words were deeply poignant and the message of “don’t be afraid to embrace the pivot”, seeing it as an opportunity to step into something new, was taken to heart by

many in the marquee, as they step beyond BGS into the world of higher education or work.
Acting Head, Mr John Gardner commented: “We were thrilled to welcome Sally to BGS. She was truly inspiring, and her speech embodied the outlook that we hope our students will live by. Being bold enough to follow their dreams, using their creativity and imagination to create a life they want to live, and being humble enough to reflect on the idea of embracing the pivots. Sally’s description of a life as a leading broadcaster was fascinating. I am sure she has motivated many of our students and her words will stay with us all.
“Prize Giving is always a day for the school community to come together to celebrate each other and reflect on their individual achievements. I love the cheering and wild applause the students show for their contemporaries and fellow classmates as the prize-winners’ names are called. It is an incredibly special day in the school calendar and having Sally join us made it especially memorable.”


The annual Fine Art and Textiles Design Summer Show is a vibrant celebration of creativity, showcasing the remarkable artistic journeys undertaken by students across all year groups. This year’s exhibition offered visitors a rich insight into the diverse projects and exceptional talent on display.
Head of Art and Textiles, Mrs Christina Lugsden, reflected on the significance of this year’s show: “We were delighted to welcome parents, students, and members of the school community to this year’s Fine Art and Textiles Design Summer Show. The exhibition offered a rich insight into the diverse projects students have undertaken, showcasing the breadth and depth of their talent in a beautifully curated display of drawing, sculpture, textiles, printmaking and mixed media work.”
The exhibition began with the expressive and emotive work of Year 9 Fine Art students, whose charcoal drawings were inspired by the haunting intensity of Käthe Kollwitz. These pieces were charged with emotion and bold mark-making, demonstrating an understanding of surface and mood. Alongside these stood delicate yet powerful clay sculptures of hands, reflecting the influence of Shirin Neshat, capturing gesture and storytelling whilst inviting viewers to consider the role of hands in expression and identity.
In Year 9 Textiles Design, students explored natural forms through the lens of William Morris, producing intricately lino-printed cushions and skirts. With strong botanical motifs and a sophisticated use of repeat patterns, the work was both technically accomplished and aesthetically refined, offering a contemporary homage to Morris’s enduring legacy.

Mrs Lugsden explained the progression evident in the GCSE work: “Our GCSE Fine Art students presented outcomes from their Still Life project, a unit that saw them work across media such as painting, drawing, etching and lino printing. Artists including Patrick Heron, Giorgio Morandi, and Ben Nicholson provided key inspiration, and students responded with carefully observed and thoughtfully composed works that balanced personal expression with a formal command of their chosen techniques.”
She continued: “In their independent projects, themes ranged from portraiture and human identity to townscapes and landscapes, demonstrating students’ ability to take ownership of their creative journeys and develop unique visual voices.”
The A Level Fine Art work reflected the highest level of individual enquiry and experimentation. The exhibition included a vast array of media, from delicate drawings and intricate printmaking to ambitious sculpture and immersive installations. Students approached their themes with conceptual rigour and technical skill, with many works pushing boundaries both in content and form. Their sketchbooks and development work, on display alongside final outcomes, offered fascinating insight into the thinking and process behind the finished pieces.



In GCSE Textiles Design, students explored the theme of ‘Overgrown’ through an exciting felting project. Rich textures, layered surfaces, and an organic colour palette brought their interpretations of decay, growth, and nature to life. The independent projects tackled a range of themes including architectural structures, cultural identity and a sense of space and place, with students combining traditional and experimental textile techniques to create striking and meaningful outcomes.
Mrs Lugsden praised the exceptional A Level Textiles Design work: “Finally, the A Level Textiles Design work was nothing short of exceptional. Students demonstrated a deep commitment to experimentation and creative risktaking, developing their ideas through a wide range of processes including stitch, dye, embellishment, digital print and garment construction.

Their final pieces included couture-inspired fashion, sculptural textiles, and highly refined sample collections. Each piece was underpinned by a strong conceptual foundation and an impressive technical fluency.”
Mrs Lugsden concluded: “The Summer Show not only celebrated the students’ achievements but also highlighted the importance of creative education in fostering critical thinking, personal growth, and problemsolving. It was a celebration of creative process, persistence, and imagination. The work on display was a testament to the dedication and vision of our artists and designers, as well as the passionate support of their teachers. We are incredibly proud of all our students and look forward to seeing where their creative journeys will take them next.”


Every now and then, someone steps forward whose actions don’t just make the news — they leave a mark on how we think about the world, and even how we see ourselves. For me, Christina Adane is one of those people. She’s younger than I am, yet her determination and calm confidence have reshaped how I understand what it means to stand up for something that matters.
When she was just 16, Christina started a campaign that made the government change its mind and in doing so, helped feed hundreds of thousands of children. You’d expect someone that age to still be figuring things out, but she showed a level of clarity and care that many adults never reach. She’s proof that being young doesn’t mean you can’t make a real difference. In fact, it might be your greatest strength.
Back in April 2020, right in the middle of the first wave of the pandemic, the government announced that free school meals would not be extended over the summer holidays. At the time, more than 1.3 million children in England relied on those meals. For many, they were already living with the stress of not knowing when their next proper meal might come.
Christina, a student from South London, knew this wasn’t right. So, she acted. She launched a petition, calling on the government to rethink its decision. It quickly went viral, gaining over 450,000 signatures and drawing nationwide attention. With the support of public figures like Marcus Rashford, the campaign worked: the government reversed its decision and extended the meal provision over the summer.
That outcome alone is huge. But what stood out to me even more was how she carried herself. Christina didn’t raise her voice or push herself into the spotlight; she simply spoke with calm, steady conviction, letting bigger names like Rashford take the fame and public adoration.
Content with the outcome, Christina did not stop there.
She joined Bite Back, a youth-led movement fighting for a healthier, fairer food system. Through this, she’s been challenging the way unhealthy food is targeted at young people and raising awareness about how poverty and race are connected to nutrition and health.


Some of the statistics from Bite Back are hard to ignore:
• Children from the poorest areas are twice as likely to live with obesity.
• Junk food companies spend ten times more on adverts than the government does promoting healthy eating.
• A significant number of schools, 3,411, have a major food chain within a 400-meter radius, a 5-minute walk, with an increase of nearly 1,000 schools compared to 2014.
Christina has taken those figures and turned them into fuel for action. She’s spoken in Parliament, fronted national campaigns and become part of an important conversation around food justice and youth voice.
Part of why Christina’s story speaks to me so strongly is because of what she stands for. Her and I both being children of immigrant families who faced hardship in many ways, she represents voices that are so often overlooked when decisions are made. She challenges the idea that only a certain type of person gets to be heard or gets to lead.
In a 2021 interview, Christina said something that I’ve thought about often since reading it:
“I think youth is my power, and being so young, that’s what shocks people into listening.”
That hit me. It’s not just a line, it’s a challenge. A reminder that we shouldn’t wait to feel “ready” before we act. Christina shows that making change is not about age, it’s about having something worth standing up for.
Since starting her campaign, Christina’s been recognised around the world. She was named one of the BBC’s 100 Women in 2020. She’s written for The Guardian, been on national news, and helped shape conversations about public health, all before turning 18.
Yet despite all that, she’s still focused on the bigger issues: making food systems fairer, improving mental health support for young people and making sure youth voices are actually heard where it counts.
Christina is a living example of what it means to be Bold, Imaginative and Reflective; her values and action align with the ethos of our school. She did not wait for someone to give her permission. She saw a problem, cared enough to do something about it and brought others along with her.
To me, she’s more than an activist, she reminds us of what’s possible.
Have the courage to start changing the things we can no longer accept.